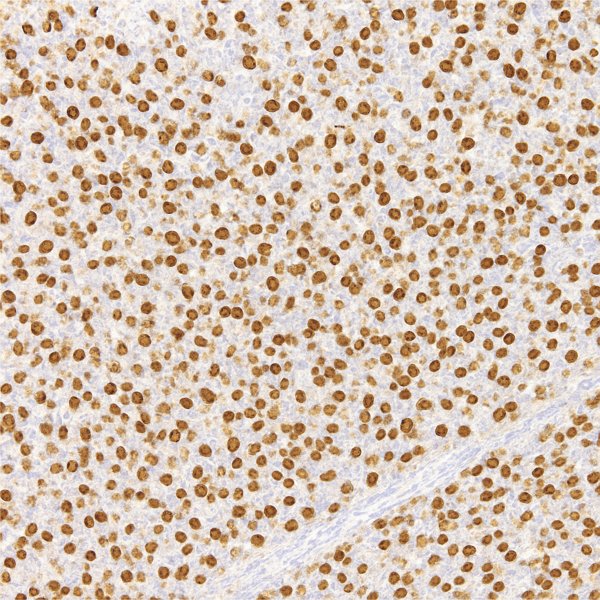

Cyclin D1 Antibody (Immunohistochemistry)
The Cyclin D1 Antibody is a key immunohistochemical marker used for detecting Mantle Cell Lymphoma (MCL) and other tumors such as breast, colon, prostate, melanoma, and parathyroid adenomas.
Cyclin D1 is a cell cycle regulatory protein that controls the transition from the G1 to S phase by activating the Cyclin D1–CDK4/6 complex, promoting cell proliferation.
Overexpression or gene amplification of Cyclin D1 plays a critical role in the development of various human tumors, making it a valuable molecular marker in both clinical diagnosis and research.
Positive staining is typically nuclear, appearing as brown coloration in tumor cells, indicating abnormal cell proliferation.
🔬 Features and Benefits Cyclin D1 Antibody
-
Specific marker for Mantle Cell Lymphoma and carcinomas
-
Distinct nuclear brown staining
-
Useful for studying cell cycle regulation and oncogenesis
-
Compatible with standard IHC protocols
-
Excellent stability: 18-month shelf life at 2–8 °C
💡 Diagnostic Applications
-
Detection of Mantle Cell Lymphoma (MCL)
-
Evaluation of breast, prostate, and colon carcinomas
-
Research on cell cycle and tumor proliferation mechanisms
-
Differentiation between neoplastic and reactive lymphoid proliferations
🌐 Fardad Azma Rad Co.
Fardad Azma Rad Co., the exclusive representative of Talent Biomedical in Iran, provides high-quality immunohistochemistry antibodies, including Cyclin D1.
With dedication to scientific accuracy, diagnostic precision, and international standards, the company supports pathology laboratories and molecular diagnostic centers across Iran.

There are no reviews yet.